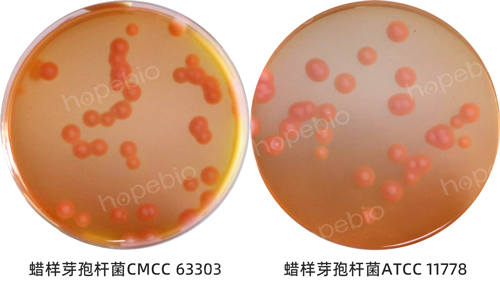

海博微信公众号
海博微信公众号
 海博天猫旗舰店
海博天猫旗舰店


 海博微信公众号
海博微信公众号
 海博天猫旗舰店
海博天猫旗舰店




一、简介
蜡样芽孢杆菌(Bacillus cereus)是一种杆状的革兰氏阳性细菌,兼性厌氧,可产生耐热芽孢。蜡样芽孢杆菌广泛存在于自然界中,可经污染食物引起多种食源性疾病。
蜡样芽孢杆菌是条件致病菌,主要通过产生腹泻毒素和呕吐毒素,引起呕吐型和腹泻型两种形式的食物中毒。也可通过菌体感染引起眼部感染、脑膜炎和菌血症等其他局部和系统性感染。腹泻毒素是一种分子量为38000u~46000u的蛋白质,有抗原性。其症状为多为水样腹泻、腹部痉挛和疼痛。因食用受到污染的肉类、海鲜、乳品或蔬菜等食物引起,潜伏期一般为6h~15h,一般持续24h。呕吐毒素是一种分子量为1153.38u的环形多肽,无抗原性。该毒素在食物中预先产生且非常稳定,进入人体后可引起呕吐。所以尽管有时食物中检出的蜡状芽孢杆菌数量很少,但仍能引发中毒。呕吐型食物中毒的潜伏期一般为0.5h~6h,常见于富含淀粉质的食品,特别是炒饭和米饭。主要症状为恶心、呕吐,有时伴有腹泻、头晕、发烧和四肢无力等症状。
因此,蜡样芽孢杆菌是食品中需要进行严格控制的微生物,本文主要依据GB 4789.14-2014《食品微生物学检验 蜡样芽胞杆菌检验》(以下简称《国标》),采用平板计数法,介绍食品中蜡样芽孢杆菌的分离和纯化过程。
二、平板计数法检测蜡样芽孢杆菌流程
本文以奶粉为供检品,演示采用平板计数法的蜡样芽孢杆菌分离纯化流程,如图1。包括供检样品的制备、供检品稀释涂布、蜡样芽孢杆菌的涂布结果展示及纯化结果等。

图1 蜡样芽胞杆菌平板计数法检验程序
1、供检样品的制备
称取奶粉样品25g,放入盛有225mL的PBS或生理盐水的无菌均质袋中,用拍击式均质器拍打1min~2min,作为1:10的样品匀液(如图2)。若样品不同,也可选用其它方法进行均质混匀,具体操作参照《国标》进行。

图2 样品的初步称量和均质
2、配制甘露醇卵黄多粘菌素琼脂基础和营养琼脂
采用甘露醇卵黄多粘菌素琼脂基础(MYP, HB0248),按照标签用法配制培养基,灭菌后,待培养基冷却至50℃时,每瓶加入50%卵黄乳液5mL及多粘菌素B 10000IU,摇匀,倾入无菌平皿,平板制备可参考操作视频:甘露醇卵黄多粘菌素平板的制备要点。或采用甘露醇卵黄多粘菌素琼脂平板(MYP, 9cm),无需制备平板,可直接使用。

图3 蜡样芽胞杆菌平板计数法检测所用到的甘露醇卵黄多粘菌素琼脂培养基
采用营养琼脂(NA, HB0109),按照标签用法配制培养基,灭菌后摇匀,倾入无菌平皿。或采用营养琼脂平板(NA, 9cm),无需制备平板,可直接使用。

图4 蜡样芽胞杆菌平板计数法检测所用到的营养琼脂培养基
3、供检样品的稀释与涂布
(1)吸取制备好的1:10的样品匀液1mL加到装有9mL PBS或生理盐水的稀释管中,充分混匀制成1:100的样品匀液。跟据对样品污染状况的估计,按上述操作,依次制成十倍递增系列稀释样品匀液。每递增稀释1次,换用1支1mL无菌吸管或吸头。
(2)根据对样品污染状况的估计,选择2个~3个适宜稀释度的样品匀液(液体样品可包括原液),以0.3mL、0.3mL、0.4mL接种量分别移入三块MYP琼脂平板,然后涂布整个平板,注意不要触及平板边缘。使用前,如MYP琼脂平板表面有水珠,可放在25℃~50℃的培养箱里干燥,直到平板表面的水珠消失。
4、分离与纯培养
(1)在通常情况下,涂布后,将平板静置10min。如样液不易吸收,可将平板放在培养箱30℃±1℃培养1h,等样品匀液吸收后翻转平皿,倒置于培养箱,30℃±1℃培养24h±2h。如果菌落不典型,可继续培养24h±2h再观察。在MYP琼脂平板上,典型菌落为微粉红色(表示不发酵甘露醇),周围有白色至淡粉红色沉淀环(表示产卵磷脂酶)。
(2)从每个平板(符合要求的平板)中挑取至少5个典型菌落(小于5个全选),分别划线接种于营养琼脂平板做纯培养,30℃±1℃培养24h±2h,进行确证实验。在营养琼脂平板上,典型菌落为灰白色,偶有黄绿色,不透明,表面粗糙似毛玻璃状或融蜡状,边缘常呈扩展状,直径为4mm~10mm。
5、培养结果展示
在甘露醇卵黄多粘菌素琼脂基础(MYP)平板上,培养后蜡样芽孢杆菌菌落呈微粉红色,周围有白色至淡粉红色沉淀环(如图5)。在营养琼脂平板上典型菌落为灰白色,偶有黄绿色,不透明,表面粗糙似毛玻璃状或融蜡状,边缘常呈扩展状(如图6),直径为 4mm~10mm。
图5 甘露醇卵黄多粘菌素琼脂平板上部分细菌形成菌落的结果

图6 营养琼脂平板上蜡样芽孢杆菌形成菌落的结果
三、食品样品中蜡样芽孢杆菌的分离纯化过程中用到的产品
整个测定过程可能用到培养基和相关产品的信息汇总如表2,客户可根据自己的需求进行选用。
表2 平板计数法测定蜡样芽孢杆菌过程中所涉及产品展示
|
培养基 |
货号 |
用途 |
|
HB0248 |
用于蜡样芽孢杆菌的固体平板计数(GB、SN标准) |
|
|
HBPM0248 |
用于蜡样芽孢杆菌的固体平板计数 |
|
|
营养琼脂 |
HB0109 |
用于一般细菌培养、转种、复壮和增菌等 |
|
HBPM003-6 |
细菌计数、不含糖,可作血琼脂基础和传代用 |
注:本文属海博生物原创,未经允许不得转载。
上一篇:2025版GB4789.30单增李斯特氏菌检验标准主要变化解读
下一篇:没有了!
| 相关文章: | ||



